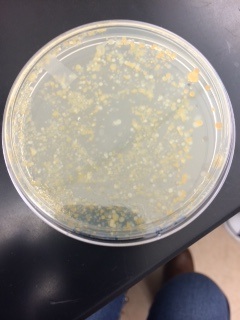
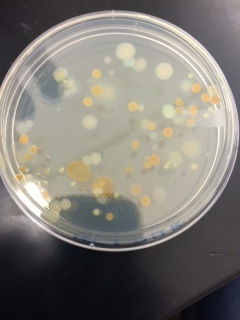
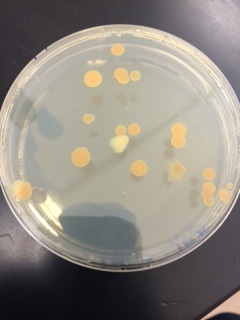

User:Alexandra Schultz/Notebook/Biology 210 at AU
March 6, 2015: Embryology & Zebrafish Development UPDATE
Friday, Day 15
All of the control and caffeine fish have died.



Conclusion: Both groups of fish died, meaning that we cannot assume that caffeine was the reason for the death of the caffeinated fish. The fish were both approximately 5 mm in length. The only real difference observed throughout the experiment was the slower reaction time for the caffeine fish.
4.7.15 The zebrafish entries are a little difficult to follow as are a little mixed up. Not a lot of information on experimental set-up. SK
ALS
March 2, 2015: Embryology & Zebrafish Development UPDATE
Monday (Day 11):
control: 12 living, none dead
stage: I
length:5.5 mm
greatly reduced movement from last observations, still moving faster than their caffeinated counterparts

caffeine: 7 living, 1 dead
stage I
length: 4 mm

Conclusion: Not much has changed since we last observed our fish. The control group has grown a little more, but the caffeine group has not grown.
ALS
February 27, 2015: 16S Sequence
Purpose: The purpose of this lab was to understand how DNA sequences are used to identify species. DNA was isolated from the bacteria colonies in our transect and PCR was used to amplify the 16S rRNA gene. This sequence is specific to each species.
Materials: The only materials used in this lab were the 16S sequencing of the specific bacteria and a laptop.
Data & Observation: The bacteria were already run through the PCR machine and the DNA sequences were amplified. One colony from the plate with tetracycline and one colony from the plate without tetracycline were used. Each colony was placed in 100 microliters of water and incubated at 100 degrees Celsius for ten minutes. The samples were then centrifuged for five minutes at 13,400 rpm. 20 microliters of primer/water was added to the PCR tube and 5 microliters of the supernatant was transferred from the centrifuged sample to the 16S PCR reaction.
After the bacteria was put through the PCR machine, they were placed on an agarose gel. In our experiment, there was a PCR product. This could be seen by the band that formed, meaning that there was a match. This meant that the DNA could be sent out for sequencing. The picture below is of the results of the gel electrophoresis.
This lab focused on examining the results of the amplification. The two samples sent our were MB38 (white nutrient plate) and MB31 (white tetracycline plate). The results were as follows; MB38 had a closest match to Pseudomonas fluorescens and MB31 had a closest match to Ralstonia pickettii.
 This was the DNA sequence for the white nutrient plate.
This was the DNA sequence for the white nutrient plate.
 This was the DNA sequence for white tetracycline plate.
This was the DNA sequence for white tetracycline plate.
Conclusion: Since the 16S rRNA gene is specific to each species, we were able to identify the types of bacteria that were growing in our transect. Our observations of our white nutrient plate were cocci & rod shaped, small, gram-positive and moving in a swimming motion. Our observations for our white tetracycline plate were rod shaped, gram-negative, and moving in a Brownian motion. The white nutrient plate was Pseudomonas fluorescens. Pseudomonas fluorescens are rod-shaped, gram-negative, and have flagella (Persson et al). Our research showed the bacteria being gram-positive, but this could have been a human error. This type of bacteria is known to live in soil, which is where we found it. The white tetracycline plate was Ralstonia pickettii, which is gram-negative and rod shaped. This strain is usually found in moist environments, which would make sense that we found this in the soil of our transect (Ryan et al). All of the observations we made on this bacteria matched up with the description online of Ralstonia pickettii.
Citations: Bentley, M., Walters-Conte, K., & Zeller, N. 2015. A Laboratory Manual to Accompany: General Biology II. American University: Washington, DC.
Ryan, Michael P., Pembroke, Tony J., & Adley, Catherine C. 2011. Genotypic and phenotypic diversity of Ralstonia pickettii and Ralstonia insidiosa isolates from clinical and environmental sources including High-purity Water. Diversity in Ralstonia pickettii. BioMed Central Ltd.
Persson, Anders, Österberg, Eva, and Dostalek, Milan. Biosurfactant production by Pseudomonas fluorescens 378: growth and product characteristics Applied Microbiology and Biotechnology.
ALS
February 27, 2015: Embryology & Zebrafish Development UPDATE
Thursday, February 26, 2015 at 6pm This was day 7. The task was to observe the zebrafish, remove the dead zebrafish and gunk, remove 10 mL of water/caffeine water and add fresh 10 mL back.
Control group: none dead, 12 still alive and hatched all in stage I (120+ hours) length: about 5 mm long The pictures below are fish in the control group
Caffeine group: 2 dead, 8 alive and hatched all in stage I (120+ hours) length: 4 mm This group is not moving as much as the control group The picture below is a fish in the caffeine group
Conclusion: The dead/alive ratio between the two groups is not substantial. The control group has four more alive fish than does the caffeine group. The major difference seen between the two were the reflexes and response time. The control group are constantly moving around while the caffeine group only really moves when the petri dish is gently shaken. Even after a gentle shake, some fish remain still. Both groups move very fast when they are active, almost like a shaking motion.
ALS
February 23, 2015: Embryology & Zebrafish Development UPDATE
Friday, February 20, 2015 at 4pm The task for Friday was to check to make sure all of the zebrafish did not die and to clean out the dead zebrafish.
Control group: none dead, alive embryos all in stage 20-somite
Caffeine group: 3 dead, alive embryos all in stage 20-somite
 This picture is an embryo without caffeine.
This picture is an embryo without caffeine.
 This picture is an embryo with caffeine.
This picture is an embryo with caffeine.
Monday, February 23, 2015 at 12pm The task for Monday was to feed the hatched zebrafish, observe the zebrafish, remove the dead zebrafish and gunk, remove 10 mL of water/caffeine water and add fresh 10 mL back.
Control group: 8 dead, 12 alive (stage: 2 in 48hr, 10 in H-I) Heart beat: 150 bpm Length: 3 mm Overall observation: Out of the 12 zebrafish left, 10 were swimming about. They move very fast and look like they are shaking.
Caffeine group: 7 dead, 10 alive (stage: 7 in H-I, 3 in 28 hr) Heart beat: 122 bpm Length: 3 mm Overall observation: Out of the 10 zebrafish left, 7 were swimming fast.
 This is a picture of the zebrafish without caffeine.
This is a picture of the zebrafish without caffeine.
These pictures to the right are zebrafish with caffeine


Conclusion for both days: There seems to be little effect of caffeine to zebrafish so far. They both have fish that are about 3 mm long and both groups have around the same amount of embryos not yet hatched. The caffeine group does have a lower heartbeat, but not by much.
ALS
February 18, 2015 (starting date): Embryology & Zebrafish Development
Purpose: The purpose of this lab was to learn the stages of embryonic development, compare embryonic development in different organisms, and set up an experiment to study how environmental conditions affect embryonic development. A single cell produced by sexual reproduction is called a zygote. The zygote will keep dividing until eventually it reaches a functional organism. Embryology is the sequence of events that follow the division of the zygote into an organism. Within embryology there is growth; increase of the structural size, differentiation; specialization of cells, and morphogenesis; the development of pattern, shape, and form. Nourishment must be provided in order for embryogenesis to continue. In invertebrate, isolecithal is the term used for the type of fertilized eggs produced. These eggs have yolks that provide the nourishment for the embryo. Fertilized eggs either develop in a holoblastic pattern or meroblastic pattern, meaning that blastomeres are formed or the mass of yolk is larger than the area of developing cells. After embryogenesis comes cleavage. Cleavage of the cell is when the cell starts to divide. Gastrulation is when the cells formed during cleavage migrate to different areas forming the ectoderm, mesoderm, and endoderm.
Materials: The materials needed for this lab were zebrafish embryos, petri dishes, 25g/mL caffeine water, water with methylene blue, pipettes, a dissecting microscope, and prepared plates of different embryos.
Data & Observation: The next procedures involve observing embryos from different organisms. Table 1 shows the data of these procedures.
Procedure 1: Starfish (Asterias Development) Fertilization of these embryos are external. These eggs are isolecithal because the yolk is distributed evenly. The blastula is the blastocoel, which then invaginate to form a gastrula and archenteron. The archenteron will become the digestive track. The ectoderm forms the skin and nervous system, the endoderm forms the digestive tract, and the mesoderm forms the tissues and circulatory system. Bipannaria larva is the motile and feeding stage.
Procedure 2: Frog Development Fertilization occurs through amplexus for frogs. The male will squeeze the female until she releases her eggs and then he will release his sperm. The embryo will have an animal pole and a vegetal pole. Cleavage is holoblastic and the yolk is telolecithal. Cleavage will lead to morula, which will have small cells called micromeres and large vegetal cells called macromeres. During gastrulation, a blastopore will form. Some yolk cells will protrude as a yolk plug through the blastopore. Gastrulation is then followed by neurulation, a forming of the neural tube, and organogenesis.
Procedure 3: Chick Development Fertilization of the egg takes place internally. The egg cell is a large yellow mass of yolk with the germinal disk on the surface. Chick eggs cleavage meroblastically to produce a blastodisk. The opening of the blastodisk during gastrulation is called the primitive streak. The embryo will develop in a hard shell for protection.
Procedure 4: Human Development Human eggs develop isolecithally and the cleavage is holoblastic. The blastocoel is called the embryoblast during blastulation. The blastocyst will implant in the uterus 8-10 days after fertilization. The placenta will nourish the embryo.
Table 1: Comparison of embryological features of developing starfish, frog, chick, and human

Conclusion: It is important to study the development of embryos to understand different organisms. Frog, chick, starfish, and human embryos all develop with some differences and also have some similarities.
Citations: Bentley, M., Walters-Conte, K., & Zeller, N. 2015. A Laboratory Manual to Accompany: General Biology II. American University: Washington, DC.
ALS
2.24.15 Good entry. Missing detail in methods section. Food web is a little simple and not really a 'web'. SK
February 16, 2015: Invertebrates
Purpose: The purpose of this lab was to understand the importance of invertebrates and to learn how simple systems evolved into more complex systems. Invertebrates make up a vast amount of organisms on this earth. Sponges, belonging to Porifera, are a type of invertebrate that do not form tissue. Cnidaria and Ctenophora have radial symmetry, which means they have a sphere with no front. The other type of symmetry is bilateral symmetry, which consists of a head and a tail. The three types of embryonic or germ tissue are ectoderm, endoderm, and mesoderm.
Materials: Materials needed were the Berlese Funnel, petri dish, microscope, and a pencil.
Data & Observations: Before observing our own transect, we had to have a basic understanding of how to identify different types of invertebrates.
Procedure 1: Acoelomates, Pseudocoelomates, and Coelomates Observe the acoelomate, Planaria, to see the mechanism of movement. Next, observe the nematodes and their movement. Lastly, observe the coelomate Annelida. The movement of all three organisms was slow and curling. All three organisms move in the same manner because they each have bilateral symmetry. Their heads and tails allow them to slink forward.
 We could observe the movement of earthworms by watching them dig through the soil.
We could observe the movement of earthworms by watching them dig through the soil.
Procedure 2: Arthropods Observe organisms from the five major classes: arachnida, diplopoda, chilopoda, insect, and crustacea.
Procedure 3: Berlese Funnel We identified two types of invertebrates from our transect. The largest organism was the Springtail while the soil mite was the smallest. The most common invertebrate in our leaf litter was the soil mites, because they could be found all throughout our leaf litter.
Procedure 4: Vertebrates and Niches Five vertebrates that inhabit our transect are springtails, soil mites, crickets, robins, and chickadees.
Classifications: Springtails: arthropoda -> entognatha -> collembola -> hypogastruridae -> hypogastrura -> H. nivicola Soil mites: arthropoda -> arachnida -> oribatida Crickets: arthropoda -> insecta -> orthoptera -> gryllidae Robins: Chordata -> aves -> passeriformes -> turdidae -> turdus -> T. migratorius Chickadees: chordata -> aves -> passeriformes -> paridae -> poecile -> poecile atricapillus
The springtails and soil mites would benefit from the plants and bacteria such as the paramecium found in the tranect. The robins and chickadees ould benefit from the crickets living in the transect because they would be a source of food. The transect also allows for shelter for some of these organisms.
These organisms represent the ecological concepts of community, carrying capacity, and trophic levels. They are all living together in a community, benefiting one another. The amount of organisms that can sustain life in a given space is the carrying capacity. These organisms can not surpass the carrying capacity of the transect because they transect would not be able to offer enough resources to the organisms if there were too many of them. Each organism is in a different trophic level, which means they gain their energy through different methods. Without one trophic level, the organisms could not live.
Conclusion: Our transect held invertebrates that we could not see with our naked eye. After using the Berlese Funnel, we were able to use a microscope to see the invertebrates.
Citations: Bentley, M., Walters-Conte, K., & Zeller, N. 2015. A Laboratory Manual to Accompany: General Biology II. American University: Washington, DC.
2.19.15 Excellent lab book entry. Included all relevant data and description of procedures SK
ALS
February 11, 2015: Plantae and Fungi
Purpose: The purpose of this lab was to understand the characteristics and diversity of plants and acknowledge the importance of Fungi. The first task was to observe plants. Plants are believed to have come from green algae and the earliest of plants resembled Bryophytes. From Bryophytes came the Tracheophytes, plants that lived during rapid emergence of new species. Angiosperm are the plants that are commonly seen today. The plants observed in this lab were examined for presence of vascularization, presence of specialized structures, and mechanisms of reproduction. The second task was to observe fungi. Fungi are decomposers that are a vital part of our world. The lineage of fungi can be broken down into three lines; zygomycota, basisiomycota, and ascomycota.
Materials: Five leaf litter samples from transect, plastic bag, and microscope.
Data & Observations: Procedure 1 was to collect the five plant samples from the transect. Below is a picture of the five specimens.

The first leaf was found on top of the ground in the west. The second leaf was found growing in the ground in the middle of the bushes. The third leaf was found on a rose bush. The fourth and fifth leaves were found next to each other towards the east. It was difficult to see the cluster arrangement of the leave because the leaves on the bush and the ground were dead. Leaf number 3 was identified as a rose bush leaf.
Procedures 2, 3, and 4 all dealt with looking at characteristics and functions of the leaves. Plant vascularization differs in land plants versus aquatic plants. Aquatic plants and mosses have rhizoids, which allow the plant to spread along the ground and obtain water. Land plants, also known as angiosperm, have xylem and phloem in order to obtain water and nutrients. All five of the leaf specimens had xylem and phloem. Specialized structures in plants can include a cuticle or stomata. All of the specimens had stomata and all but one, number 3, had a cuticle. These plants also had guard cells which control the stomata, and mesophyll which lies between the middle and upper epidermis. All land plants also reproduce through alteration of generations. Since all of our specimen were land plants, they reproduce through alternation of generations. The plants have gametophyte and sporophyte stages. The cotyledon part of the seed allows the seed to survive past the initial stages. It can either be a monocot or a dicot. All of the leaves in our transect were dicots. The table below is the data collected from each leaf.
After the plants from the transect were characterized, we moved on to fungi. We observed black bread-mold, which is of the zygomycetes line. The hyphae grows into bulbs called sporangia. The sporangia are important because inside them are the spores. Once the spores are released, the fungi can grow.
 This is what the bread mold looked like under a microscope.
This is what the bread mold looked like under a microscope.
 This is what the mushroom looked like under a microscope. Mushrooms belong to the basidiomycota line.
This is what the mushroom looked like under a microscope. Mushrooms belong to the basidiomycota line.
The last task was to set up the Berlese funnel to collect invertebrates. This was done by putting screening paper into a funnel, placing the soil and leaf sample from the transect in the funnel, and connecting the funnel to a flask filled with preserving ethanol. A lamp was then placed over the funnel and the whole thing was wrapped in foil to sit for a week. Below is a picture of our Berlese funnel.
Conclusion: Plants and Fungi play vital roles in sustaining the earth. Plants that are aquatic have a different mechanism to retain water versus plants that are found on the land. Through specialization, plants are able to photosynthesize and protect themselves from the environment. All land plants reproduce through alternation of generations, which means that they reproduce both sexually and asexually. Plants use the carbon dioxide that fungi releases in order to make carbohydrates. Fungi also fix nitrogen into the soil.
Citations: Bentley, M., Walters-Conte, K., & Zeller, N. 2015. A Laboratory Manual to Accompany: General Biology II. American University: Washington, DC.
ALS
2.10.15 Excellent lab book entry. Nice clear presentation of data. Could include some detail of the gram stain procedure or a link to a similar protocol. SK
February 4th, 2015: Microbiology and Identifying Bacteria with DNA Sequences
Purpose: The purpose of this lab was to understand the characteristics of bacteria, to observe antibiotic resistance, and to understand how DNA sequences are used to identify species. Bacteria can be identified in three different shapes; bacillus (rod), coccus (round), and spirillum (spiral). The bacteria observed in this lab were Proeobacteria, Chlamydiae, Spirochetes, Actinobacteria, Firmicutes, and Cyanobacteria. The archaea groups, Euryarchaeota and Crenarchaeota, were most likely not observed because these plates were not grown in an extreme environment.
Materials: The materials used in this lab were a microscope, slides, cover slips, the agar plates that were prepared in the last lab, a bunsen burner, and Gram's iodine mordant.
Data & Observations: Before beginning Procedure 1, we observed our Hay Infusion Culture. We noticed that the smell was not as bad as the smell given off by the Hay Infusion last week. The culture appeared to be darker, evaporation had occurred, and there was an "earthy" smell. The stench from last week could have died down because the bacteria that produced this smell are no longer alive. As time progresses, the Hay Infusion Culture cannot support the life of all of the bacteria originally living inside the culture.
Procedure 1: Quantifying and Observing Microorganisms The first task is to observe the colonies on each agar plate. Once the colonies are counted, this number can be multiplied by the conversation factor to show how many colonies are present per milliliter.
Procedure 2: Antibiotic Resistance There is a difference in the plates with antibiotics versus the plates that do not have antibiotics. There are less colonies on the agar plates that have the antibiotic present. This indicates that the antibiotic prevents the bacteria from growing and therefore means that there were some strains of bacteria that were not resistant to the antibiotic. There was a decrease in the number of bacteria in the plates that had tetracycline. There were no plates with fungi present. There were two species (out of three) of bacteria that were unaffected by tetracycline.
Tetracycline uses two resistance determinants called tet(M) and tet(O). The resistance is in pneumococcus (Widdowson 1998).
The pictures below are the plates before being touched and manipulated.
This is the 10^-5 nutrient only plate.
This is the 10^-5 nutrient only plate.
This is the 10^-7 nutrient only plate.
This is the 10^-7 nutrient only plate.
 This is the 10^-9 nutrient only plate.
This is the 10^-9 nutrient only plate.
 This is the 10^-5 tetracycline plate.
This is the 10^-5 tetracycline plate.
This is the 10^-7 tetracycline plate.
This is the 10^-7 tetracycline plate.
 This is the 10^-9 tetracycline plate.
This is the 10^-9 tetracycline plate.
Procedure 3: Bacteria Cell Morphology Observations The last procedure is to make a wet mount and to gram stain. We took two colonies from the nutrient plate and two colonies from the nutrient plus tetracycline plate. Wet mounts were made for all four samples, and each was observed under the microscope. This was done in order to see the motility of the bacteria. Below is a picture of what the bacteria looked like while in motion.
The next step was to gram stain the four colonies. Gram staining helps to determine whether or not the bacteria are gram-positive (have a thick peptidoglycan layer) or gram-negative. The bacteria that turned purple were gram-positive and the bacteria that turned red were gram-negative because the dye will only be retained in the gram-positive bacteria once it is rinsed with water. Below are pictures of the gram stain tests for the four samples.
 The above picture is the 10^-7 nutrient plate colony that was blue. It is gram-positive.
The above picture is the 10^-7 nutrient plate colony that was blue. It is gram-positive.
 The above picture is the 10^-7 tetracycline plate colony that was yellow. It is gram-positive.
The above picture is the 10^-7 tetracycline plate colony that was yellow. It is gram-positive.
 The above picture is the 10^-7 nutrient plate colony that was white. It is gram-positive.
The above picture is the 10^-7 nutrient plate colony that was white. It is gram-positive.
 The above picture is the 10^-7 tetracycline plate that was white. It is gram-negative.
The above picture is the 10^-7 tetracycline plate that was white. It is gram-negative.
Table 2 below sums up the results of each test and observation done to the bacteria samples.

Procedure IV: Set up PCR for 16S sequencing Once the lab on observing the bacteria is complete, we set up the PCR for the next lab. One sample from both the agar plate with nutrients and the agar plate with nutrients and tetracycline were taken for the PCR. The DNA from these colonies will be isolated to selectively amply the 16S rRNA gene.
Conclusions: The agar plates treated with tetracycline had less colonies form because some bacteria was not antibiotic resistant. The most common shape of our bacteria was rod shaped. All of the bacteria looked to be floating.
Citations: Bentley, M., Walters-Conte, K., & Zeller, N. 2015. A Laboratory Manual to Accompany: General Biology II. American University: Washington, DC.
CAROL A. WIDDOWSON and KEITH P. KLUGMAN. Microbial Drug Resistance. Spring 1998, 4(1): 79-84.
ALS
2.4.15 Good notebook entry. Pictures are too large and make it difficult to read the text. Try saving the images as smaller size files and then uploading them. SK
January 27, 2015: Identifying Algae and Protists
Purpose: The purpose of this lab is to practice using a dichotomous key in order to identify organisms, to understand characteristics of Algae and Protist, and to see the growth from the last week's Hay Infusion.
Materials: The materials needed for this lab were a microscope, the Hay Infusion jar, slides, cover slides, Protoslo, a dichotomous key, and six petri dishes.
Data & Observations: Before looking at the Hay Infusion, we needed to become familiarized with using the dichotomous key. In order to do so, we observed known organisms under the microscope and used the dichotomous key to see if our guesses were correct. Three organisms could be labeled using the dichotomous key. These three organisms were Colpidium sp., Euglena, and Paramecium aurelia.
 In this picture, the organism to the far left is Eudorina. Eudorina is spherical in shape, contains 32 cells, and has no cilia. The single long organism in the middle is Euglena. Euglena is green in color, long, and has one flagella. The clear cells all over the slide are Colpidium. Colpidium have small, oval shaped bodies.
In this picture, the organism to the far left is Eudorina. Eudorina is spherical in shape, contains 32 cells, and has no cilia. The single long organism in the middle is Euglena. Euglena is green in color, long, and has one flagella. The clear cells all over the slide are Colpidium. Colpidium have small, oval shaped bodies.
Once we were acquainted with using the dichotomous key, we could move on to the Hay Infusion. The Hay Infusion culture smelled like sulfur and looked completely brown. Sediment had fallen to the bottom of the jar while murky brown water stayed on the top. There is no apparent life on the top of the liquid. Once initial observations were finished, samples taken from two different niches could be observed under the microscope. The organisms in each niche may differ from one another because some organisms may spend more time by the sediment while others may stay closer to the top of the jar. Where the organisms choose to live depends on how they obtain their energy source. The first niche was at the bottom right above the sediment. Here, we found Eudorina, Paramecium aurelia, and Paramecium bursaria.
 The above picture is Eudorina and Paramecium bursaria. The Eudorina are the small circles surrounding the Paramecium bursaria. Eudorina are small, round, and green. They are algae and usually have 32 cells grouped together in the colony that move with flagella. They photosynthesize in order to obtain energy. This eudorina was 10 micrometers long. The Paramecium bursaria is the organism in the center. It has a rod shaped body and it is a protozoa. Green algae lives in this paramecium in a symbiotic relationship. Paramecium bursaria have + and - strains, which are an example of sexual dimorphism. This paramecium bursaria was 80 micrometers.
The above picture is Eudorina and Paramecium bursaria. The Eudorina are the small circles surrounding the Paramecium bursaria. Eudorina are small, round, and green. They are algae and usually have 32 cells grouped together in the colony that move with flagella. They photosynthesize in order to obtain energy. This eudorina was 10 micrometers long. The Paramecium bursaria is the organism in the center. It has a rod shaped body and it is a protozoa. Green algae lives in this paramecium in a symbiotic relationship. Paramecium bursaria have + and - strains, which are an example of sexual dimorphism. This paramecium bursaria was 80 micrometers.
 The above picture is Paramecium aurelia. Paramecium aurelia are one strain of paramecium. They are protists that are covered in cilia and can reproduce sexually and asexually. This paramecium aurelia was 120 micrometers.
The above picture is Paramecium aurelia. Paramecium aurelia are one strain of paramecium. They are protists that are covered in cilia and can reproduce sexually and asexually. This paramecium aurelia was 120 micrometers.
The second niche observed was the area on top of a flower bud in the jar. In this niche, we found Euglena, Chlamydomonas, and Paramecium multimicronucleatum.
 The above picture is Euglena. This Euglena was 40 micrometers and had a long body with one flagella. Euglena has chloroplasts so it can feed like an autotroph, but it also can feed as a heterotroph through phagocytosis.
The above picture is Euglena. This Euglena was 40 micrometers and had a long body with one flagella. Euglena has chloroplasts so it can feed like an autotroph, but it also can feed as a heterotroph through phagocytosis.
 The above picture is Chlamydomonas. Chlamydomonas is a uni-cellular green algae that has two flagella in order to move. These chlamydomonas were about 10 micrometers. Some of the chlamydomonas were as small as 5 micrometers. They photosynthesize in order to obtain energy.
The above picture is Chlamydomonas. Chlamydomonas is a uni-cellular green algae that has two flagella in order to move. These chlamydomonas were about 10 micrometers. Some of the chlamydomonas were as small as 5 micrometers. They photosynthesize in order to obtain energy.
 The above picture is Paramecium multimicronucleatum. Paramecium multimicronucleatum are the largest of the parameciums. The organism we observed was 200 micrometers long. They are a protist that move with cilia. They are heterotrophs that use a mouth opening to obtain food.
The above picture is Paramecium multimicronucleatum. Paramecium multimicronucleatum are the largest of the parameciums. The organism we observed was 200 micrometers long. They are a protist that move with cilia. They are heterotrophs that use a mouth opening to obtain food.
The last step for this lab was to prepare and plate serial dilutions for next week's lab. Below is a diagram of how we did this.

Conclusions: By observing different types of protists and algae, we could see evolution and certain characteristics that help group organisms into certain categories. Euglena meets all the needs of life because it photosynthesizes for food, it is a single cell, it has a flagellum that helps it swim and respond to the environment, it reproduces by using a binary fission and cell division, and it has adapted and evolved from other species.
If the Hay Infusion grew for another two months, I would expect to see many more protists and bacteria. The selective pressures that would affect the community in the sample would be a fight for food and space. There can only be a certain amount of organisms living in the Hay Infusion before they all run out of resources and die.
Citations: Bentley, M., Walters-Conte, K., & Zeller, N. 2015. A Laboratory Manual to Accompany: General Biology II. American University: Washington, DC.
ALS
1.27.15 Missing a lot of information. Need to address all red text in manual and organize lab into: Purpose, Materials, Data & Observations, Conclusions. Need to include picture of transect and describe Hay Infusion set-up. Transect is 20ft by 20ft there is a typo in the manual. SK
January 15th, 2015: Biological Life at AU
Purpose: In this lab, we observed evolution by looking at Chlamydomonas, Gonium, and Volvox. These organisms are all members of the Volvocine Line. Number of cells, colony size, specialization, motility, and sexual reproduction were all taken into account.
Materials: Slides with organisms, microscope, paper, pen for procedure one. Pencil, paper, jar, soil collection from transect, dried milk, and deerpark water for procedure two.
Data & Observations: Procedure 1: The Volvocine Line Observe Chlamydomonas, Gonium, and Volvox for certain characteristics in order to see similarities and differences.
Procedure 2: Observing a Niche at AU Observe the ecology at American by looking at a 20x20 ft transect in front of Hurst. The transect observed had both abiotic and biotic components. Abiotic components in this transect were soil, snow, a fork, wood chips, and cement. Biotic components in this transect were grass, flower buds, leaves, flower bushes, and a spider.
After samples were taken from our transect, we made a Hay Infusion Culture. To do this, dried milk and deerpark water were added to our soil that we collected. The Hay Infusion Culture sat in the lab for a week without a lid.
Conclusions: Evolution could be explained by looking at the different lines of Volvocines. As this line evolved,the organisms grew in cell size and colony size. Sexual reproduction also became more complex as these organisms evolved. The transect section of this lab showed the different types of biotic and abiotic components in one given area. This transect allowed us to gather soil and other elements in order to make a Hay Infusion for next week's lab.
Citations: Bentley, M., Walters-Conte, K., & Zeller, N. 2015. A Laboratory Manual to Accompany: General Biology II. American University: Washington, DC.
ALS
















